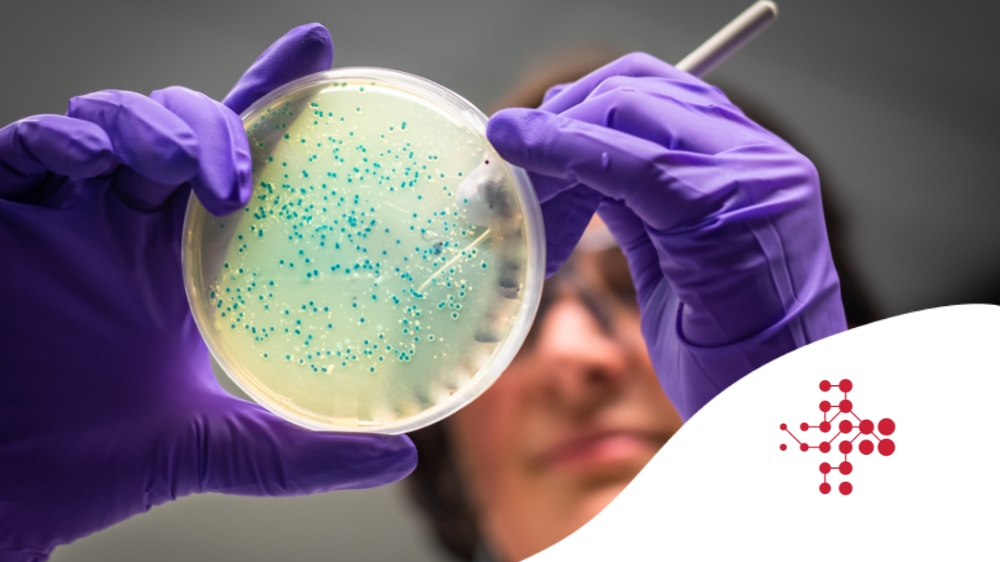

Skrytý hráč střevního mikrobiomu: Bakterie spojená s nižším výskytem chronických onemocnění
👉 Tento text vyšel původně v newsletteru Dr. Lasso, který každý týden přináší novinky ze světa medicíny, inspirativní rozhovory a přehled nejzajímavějších výzkumů. Přihlásit se můžete na www.drlasso.com.
Co studie ukázala
Mezinárodní tým vedený University of Cambridge analyzoval metagenomická data z více než 11 000 vzorků ze 39 zemí. Zaměřil se na bakteriální skupinu CAG-170, kterou se dosud nepodařilo snadno kultivovat v laboratorních podmínkách.CAG-170 se ukázala jako nejvýraznější člen tzv. „skrytého mikrobiomu“ – skupiny mikroorganismů, které jsou konzistentně spojeny se zdravím napříč populacemi.
Vyšší hladiny CAG-170 byly opakovaně zjištěny u zdravých osob, zatímco nižší hladiny byly spojeny s chronickými onemocněními, včetně Crohnovy choroby, obezity a chronického únavového syndromu.
Metabolická role a vztah k dysbióze
Genetická analýza naznačila, že CAG-170 má schopnost produkovat vitamín B12 a štěpit sacharidy, cukry a vlákninu. Podle autorů vitamín B12 produkovaný těmito bakteriemi pravděpodobně nepůsobí přímo na hostitele, ale může podporovat další prospěšné bakterie ve střevním mikrobiomu.
Ve třech nezávislých analýzách byla nižší hladina CAG-170 spojena s dysbiózou, tedy narušenou rovnováhou mikrobiomu, která je popisována u řady chronických stavů. Studie také ukázala, že přítomnost CAG-170 souvisí se stabilitou a odolností mikrobiálního složení.
Co z toho vyplývá podle autorů
Autoři uvádějí, že CAG-170 může představovat identifikovatelný marker zdravého mikrobiomu. Výzkum vychází z rozsáhlého genomového katalogu lidského střevního mikrobiomu, který zahrnuje tisíce dosud necharakterizovaných druhů. Většinu bakterií z této skupiny se zatím nepodařilo kultivovat, což omezuje jejich experimentální testování a další klinické využití. Studie byla zveřejněna 11. února 2026 v časopise Cell Host & Microbe.
Zdroj:
University of Cambridge. Hidden gut bacteria linked to better health discovered. Publikováno 11. února 2026.
Dostupné z: https://www.sciencedaily.com/releases/2026/02/260211204210.htm
Články na podobné téma

Pacientsky orientovaná péče může snižovat úroveň stresu lékařů

Nové léky mění praxi v primární péči, ale naráží na cenu

ORL – MUDr. Radek Langer: „Začni dělat co nejdřív. Medicína není o koukání někomu přes rameno.“
Registruj se, ať ti nic neuteče
Pravidelně posíláme nejprogresivnějších newsletter českého zdravotnictví, který odebírá více než 13 000 lidí.
Staňte se naším partnerem
Buďte součástí našeho úspěšného projektu a získejte přístup k odbornému know-how a novým obchodním příležitostem.
Oslovte největší českou komunitu mediků a lékařů
Staňte se součástí našeho odborného obsahu
Postavte se po bok projektu s mimořádným přesahem
Copyright © 2025 Po medině | Zlepšujeme české zdravotnictví odspodu.















